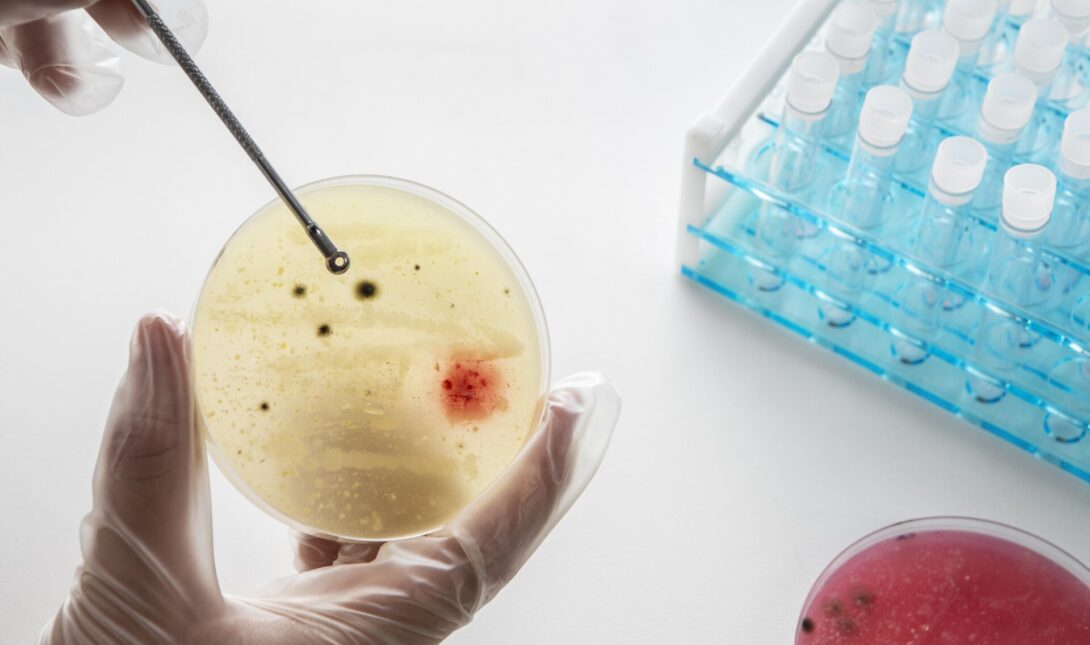
καρκίνος θεραπεία

Μια νέα οπτική για την κατανόηση και την αντιμετώπιση των αιματολογικών καρκίνων
Ο καρκίνος δεν αφορά μόνο αλλοιωμένα γονίδια – αφορά και «αλλοιωμένη αρχιτεκτονική», σαν μια πόλη όπου οι δρόμοι εξαφανίζονται ξαφνικά, αποκόπτοντας ολόκληρες γειτονιές από βασικές υπηρεσίες.
Κάτι παρόμοιο συμβαίνει μέσα στα κύτταρα όταν η τρισδιάστατη δομή του DNA καταρρέει. Νέα μελέτη που παρουσιάστηκε στο συνέδριο της American Society of Hematology (ASH) 2025 από τον Martin Rivas, Ph.D., ερευνητή στο Sylvester Comprehensive Cancer Center του Πανεπιστημίου του Μαϊάμι, αποκαλύπτει ότι ακόμη και μικρές διαταραχές στην «αρχιτεκτονική του γονιδιώματος μπορούν να προδιαθέσουν σε λέμφωμα».
Το εύρημα αυτό προσφέρει μια νέα οπτική για την κατανόηση -και στο μέλλον την αντιμετώπιση- των αιματολογικών καρκίνων. Η μελέτη, με τίτλο «SMC3 and CTCF Haploinsufficiency Drive Lymphoid Malignancy via 3D Genome Dysregulation and Disruption of Tumor Suppressor Enhancer-Promoter Loops», εισάγει μια νέα έννοια: την αρχιτεκτονική καταστολή όγκων (architectural tumor suppression). Πρωτεΐνες όπως οι SMC3 και CTCF δεν οργανώνουν απλώς το DNA, αλλά αποτρέπουν ενεργά τον καρκίνο, διατηρώντας βρόχους που συνδέουν τους «διακόπτες» των γονιδίων (enhancers) με τα γονίδια που ελέγχουν (promoters). Αν χαθεί ακόμη και το ήμισυ αυτών των πρωτεϊνών, οι βρόχοι αρχίζουν να εξαφανίζονται, καταστέλλοντας κρίσιμα γονίδια που καταστέλλουν τους όγκους.
pexels
Νέα μελέτη για τον καρκίνο: «Είναι σαν να χάνεις το σχέδιο ενός κτιρίου ενώ η κατασκευή βρίσκεται σε εξέλιξη»
«Γνωρίζουμε από καιρό ότι οι μεταλλάξεις προκαλούν καρκίνο», δήλωσε ο Rivas. «Αλλά αυτή η εργασία δείχνει ότι η αρχιτεκτονική -ο τρόπος με τον οποίο διπλώνεται το DNA- μπορεί να είναι εξίσου σημαντική. Είναι σαν να χάνεις το σχέδιο ενός κτιρίου ενώ η κατασκευή βρίσκεται σε εξέλιξη». Χρησιμοποιώντας αναλυτικά εργαλεία τεχνητής νοημοσύνης για την ερμηνεία τεράστιων συνόλων δεδομένων η ομάδα εντόπισε ένα εντυπωσιακό μοτίβο: η haploinsufficiency (μερική απώλεια) των SMC3 ή CTCF δεν καταστρέφει ολόκληρη τη δομή του γονιδιώματος.
Αντίθετα, διαβρώνει βραχείς βρόχους enhancer–promoter, το «σύστημα καλωδίωσης» που διατηρεί ενεργά γονίδια καταστολής όγκων όπως τα Tet2, Kmt2d και Dusp4. Χωρίς αυτούς τους βρόχους, τα Β-κύτταρα φτάνουν σε ένα «αδιέξοδο» και δεν καταφέρνουν να ωριμάσουν σε πλασματοκύτταρα, δημιουργώντας έτσι ένα εύφορο έδαφος για κακοήθεια. Τα εργαλεία τεχνητής νοημοσύνης βοήθησαν στην ενσωμάτωση αυτών των πολύπλοκων επιπέδων δεδομένων, αποκαλύπτοντας, πώς οι αρχιτεκτονικές αλλαγές επηρεάζουν τη γονιδιακή έκφραση και τη μοίρα των κυττάρων. «Εδώ είναι που η υπολογιστική βιολογία λάμπει», πρόσθεσε ο Rivas.
«Η τεχνητή νοημοσύνη μας επέτρεψε να δούμε μοτίβα αόρατα στο ανθρώπινο μάτι, πώς η απώλεια ενός μόνο αντιγράφου ενός γονιδίου αναδιαμορφώνει ολόκληρο το τρισδιάστατο τοπίο». Νέα μελέτη για τον καρκίνο: Τα ευρήματα στην πράξη Και τα ευρήματα δεν είναι θεωρητικά. Ασθενείς με diffuse large B-cell lymphoma (DLBCL) που έχουν χαμηλότερα επίπεδα SMC3 έχουν χειρότερη πρόγνωση. Αυτό υποδηλώνει ότι η αρχιτεκτονική του γονιδιώματος θα μπορούσε να αποτελέσει βιοδείκτη πρόγνωσης – και ίσως στόχο θεραπείας στο μέλλον.
Αντί να διορθώνονται οι μεταλλάξεις, οι θεραπείες θα μπορούσαν να στοχεύουν στην αποκατάσταση των κατάλληλων βρόχων ή στη μίμηση της λειτουργίας τους. Αυτή η έρευνα αναδιαμορφώνει τη βιολογία του καρκίνου: δεν αφορά μόνο τον γενετικό κώδικα, αλλά και τη δομή που τον συγκρατεί. Κατανοώντας την αρχιτεκτονική καταστολή των όγκων, οι επιστήμονες μπορούν να διερευνήσουν θεραπείες που σταθεροποιούν τη δομή του γονιδιώματος – ένα εντελώς νέο μέτωπο στην ογκολογία.
«Μπαίνουμε σε μια εποχή όπου η θεραπεία του καρκίνου μπορεί να σημαίνει επιδιόρθωση της αρχιτεκτονικής, όχι μόνο των “σπασμένων” γονιδίων», είπε ο Rivas.
Με πληροφορίες από MedicalXpress
Δημοφιλή
Μαύρο 24ωρο στην Κρήτη: 3 θάνατοι μέσα σε λίγες ώρες συγκλονίζουν το νησί
«Μπλόκο» του Λιμενικού στο λιμάνι του Ηρακλείου - Δύο συλλήψεις αλλοδαπών με ανακληθέντα έγγραφα
Ηράκλειο: Βαθιά θλίψη για τον θάνατο του αγαπητού εκπαιδευτικού
Πένθος στο Λασίθι για τον χαμό του αγαπητού Κωνσταντίνου στα 59 του χρόνια
«Ασυγκράτητες» οι εισροές υδάτων στο φράγμα Αποσελέμη - Δείτε βίντεο
Τραγωδία στην Ευρυτανία: Νεκρός 54χρονος σε τροχαίο - Το φορτηγό του έπεσε σε γκρεμό 40 μέτρων
Γιώργος Λιάγκας και Δέσποινα Καμπούρη «λύγισαν» στον αέρα (βίντεο)
Εντοπίστηκαν νεκρά πρόβατα εγκαταλελειμμένα στο βουνό
ΟΠΕΚΕΠΕ: Παραιτήσεις υπέβαλαν Κεφαλογιάννης, Τσιάρας, Βαρτζόπουλος - Ποιοι αναλαμβάνουν